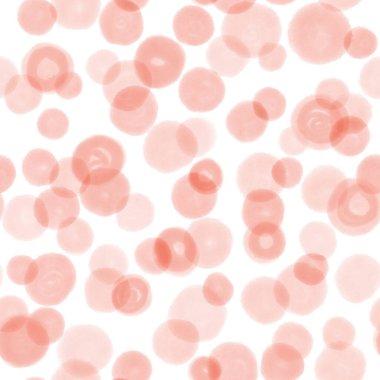
Kırmızı suluboya noktalar kusursuz desen. El çizimi çemberler arka planı tekrarlıyor. Renkli yuvarlak şekilli arka plan. Kırmızı boyalı, beyaz üzerine suluboya noktalar. Çocuklar için dekorasyon, çocuklar için kumaş, ..

Işık turuncu vektör küreler ile seamless modeli. Soyut illüstrasyon renkli baloncuklar doğa tarzı ile. Desen tasarım pencere panjur, perdeler.
Özel Boyut
(5556 x 5556, eps)
Geniş Lisanslama
(5556 x 5556, eps)
En Çok Aranan Kelimeler
RenkkürevektörYuvarlakArkaplandaireGrafikselresimlemedizaynCamparlaktarafıpartiBırakSoyutdokuTuruncuIşıkDesensatırKusursuznoktaBulanıkGeleceğe yönelikparlaDuvar KağıdıeğilimsanatsalgeometriktekerlekYarıtondöngüKulüpKabarcıkDiskdüşükbulanık mantıkturBenzer İçerikler